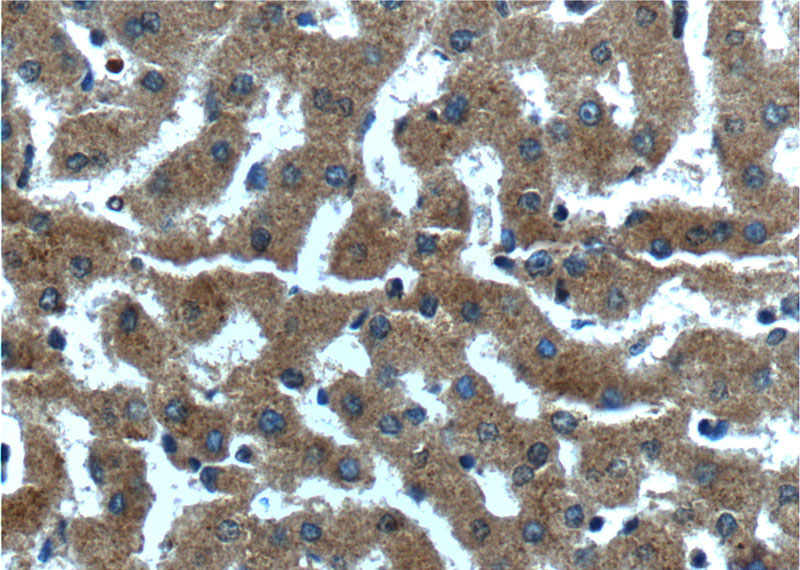
Immunohistochemistry of paraffin-embedded human liver tissue slide using Catalog No:109639(CXCL14 Antibody) at dilution of 1:200 (under 40x lens).

-
Product Name
CXCL14 antibody
- Documents
-
Description
CXCL14 Rabbit Polyclonal antibody. Positive WB detected in MCF-7 cells. Positive IHC detected in human liver tissue, human breast cancer tissue, human colon cancer tissue, human stomach tissue. Observed molecular weight by Western-blot: 14 kDa
-
Tested applications
ELISA, WB, IHC
-
Species reactivity
Human; other species not tested.
-
Alternative names
BMAC antibody; bolekine antibody; BRAK antibody; C X C motif chemokine 14 antibody; Chemokine BRAK antibody; CXCL14 antibody; Kec antibody; KS1 antibody; MIP 2g antibody; MIP2G antibody; NJAC antibody; PSEC0212 antibody; SCYB14 antibody; Small inducible cytokine B14 antibody
-
Isotype
Rabbit IgG
-
Preparation
This antibody was obtained by immunization of CXCL14 recombinant protein (Accession Number: BC003513). Purification method: Antigen affinity purified.
-
Clonality
Polyclonal
-
Formulation
PBS with 0.1% sodium azide and 50% glycerol pH 7.3.
-
Storage instructions
Store at -20℃. DO NOT ALIQUOT
-
Applications
Recommended Dilution:
WB: 1:200-1:1000
IHC: 1:50-1:500
-
Validations

MCF-7 cells were subjected to SDS PAGE followed by western blot with Catalog No:109639(CXCL14 Antibody) at dilution of 1:300

Immunohistochemistry of paraffin-embedded human liver tissue slide using Catalog No:109639(CXCL14 Antibody) at dilution of 1:200 (under 10x lens).
Immunohistochemistry of paraffin-embedded human liver tissue slide using Catalog No:109639(CXCL14 Antibody) at dilution of 1:200 (under 40x lens).
-
Background
CXCL 14 (C-X-C motif chemokine 14) is a small inducible cytokine, and may be a potent chemoattractant for neutrophils. CXCL14 possesses a destruction box (D-box) domain which acts as a recognition signal for degradation via the ubiquitin-proteasome pathway. CXCL14 is widely expressed in normal tissues including heart, brain, placenta, lung, liver, skeletal muscle, kidney and pancreas without inflammatory stimuli. It is dispensable for dendritic cell function and localization within peripheral tissues. In localized porostae cancer, CXCL14 mRNA was significantly upregulated and positively correlated with Gleason score.
-
References
- Zeng J, Yang X, Cheng L. Chemokine CXCL14 is associated with prognosis in patients with colorectal carcinoma after curative resection. Journal of translational medicine. 11:6. 2013.
- Yamazaki K, Tanigawa K, Suzuki K. Iodide-induced chemokines and genes related to immunological function in cultured human thyroid follicles in the presence of thyrotropin. Thyroid : official journal of the American Thyroid Association. 20(1):67-76. 2010.
Related Products / Services
Please note: All products are "FOR RESEARCH USE ONLY AND ARE NOT INTENDED FOR DIAGNOSTIC OR THERAPEUTIC USE"
